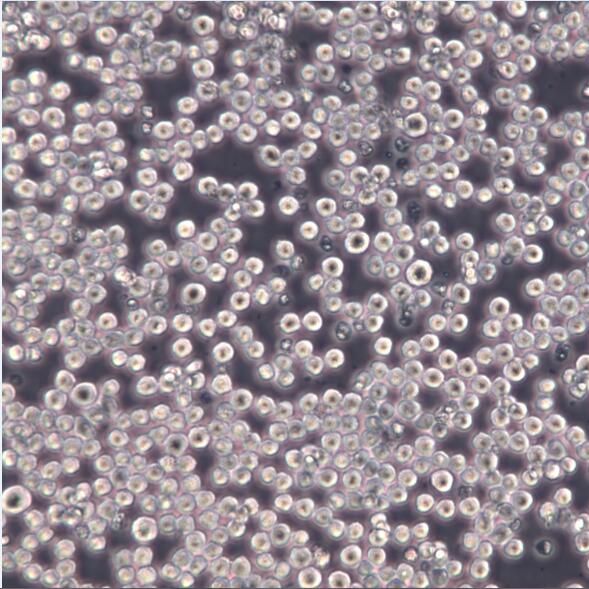
产品封面图

相关产品推荐更多 >
万千商家帮你免费找货
0 人在求购买到急需产品
- 详细信息
- 文献和实验
- 技术资料
- 英文名:
K562
- 库存:
大量库存
- 供应商:
盖宁生物
- 肿瘤类型:
白血病
- 细胞类型:
肿瘤细胞/正常细胞
- ATCC Number:
详询
- 品系:
详询
- 组织来源:
详询
- 相关疾病:
详询
- 物种来源:
人源
- 免疫类型:
详询
- 细胞形态:
淋巴母细胞样
- 是否是肿瘤细胞:
是
- 器官来源:
详询
- 运输方式:
快递托运
- 年限:
永久
- 生长状态:
良好
特别提醒:该产品仅限于实验室科学研究使用,不得用于其他用途
提供STR鉴定报告

细胞名称:K-562 人慢性骨髓性白血病细胞
组织来源:骨髓;慢性骨髓性白血病(CML)
培养条件:RPMI-1640 +10% FBS
形 态:悬浮;淋巴母细胞样
背 景:K-562由Lozzio从一位临终的53岁女性慢性骨髓性白血病患者的胸水中建立。细胞被归入高度未分化的粒性白细胞类。Anderson等对其表面膜性质的研究表明,K-562是一株人类红白血病细胞。K-562细胞株在自然杀伤分析中广泛作为高敏感的体外受体。 See Pross等将它用于NK细胞的体外详细检测,包括NK细胞活性的数学量化。 K-562母细胞是多能性,造血恶性细胞,它能自发分化成可识别的红血球祖细胞、粒性白细胞、单核细胞等。
ubMed=1103999; DOI=10.1007/BF01634146
Schwenk H.-U., Schneider U.
Cell cycle dependency of a T-cell marker on lymphoblasts.
Blut 31:299-306(1975)
PubMed=1086134
Kaplan J., Peterson W.D. Jr.
Detection of T-cell lymphoma-associated antigens on cord blood lymphocytes and phytohemagglutinin-stimulated blasts.
Cancer Res. 36:3471-3475(1976)
PubMed=68013; DOI=10.1002/ijc.2910190505
Schneider U., Schwenk H.-U., Bornkamm G.-W.
Characterization of EBV-genome negative 'null' and 'T' cell lines derived from children with acute lymphoblastic leukemia and leukemic transformed non-Hodgkin lymphoma.
Int. J. Cancer 19:621-626(1977)
风险提示:丁香通仅作为第三方平台,为商家信息发布提供平台空间。用户咨询产品时请注意保护个人信息及财产安全,合理判断,谨慎选购商品,商家和用户对交易行为负责。对于医疗器械类产品,请先查证核实企业经营资质和医疗器械产品注册证情况。
文献和实验*发表【中文论文】请标注:由上海盖宁生物科技有限公司提供;
*发表【英文论文】请标注:From Shanghai Gaining Biotechnology Co., Ltd.
mhy叶可 大家好,我是新手,第一次养细胞,恳请各位大虾给点关于培养K562以及K562/A02的建议。K562是悬浮细胞吗?还是半贴壁?半贴壁的话应该怎么换液?请各位老师不吝赐教,多谢,多谢。 yupingwang 悬浮细胞,离心后去上清,培养基重悬 mhy叶可 多谢,以后还要多多请教,呵呵 mhy叶可 请教楼上老师,k562/A02耐药细胞株培养时,怎么维持
hupengfei5566 各位大虾,我最近在做K562自噬方面的研究,但是几次Wstern Blot结果跑下来我发现一个很奇怪的现象,就是我的未处理组的K562细胞的自噬水平波动很大。按理,正常水平下自噬水平应该是比较低的,但我做的结果中第一次结果比较好,后几次发现未处理组的细胞自噬水平也很高,就好像诱导了一样,LC3-Ⅱ的表达水平比LC3-Ⅰ还要高,我在附件中放了3次的实验结果,第一孔就是我的未处理组。请高手指教。不知道大家有没有在试验中碰到过这个问题
技术、TALEN技术和CRISPR/Cas9技术的基因敲除研究。 实验流程1. 基因组DNA的准备:提取野生型和突变型细胞的基因组DNA。Genloci公司专为阳性克隆筛选设计的TNA抽提试剂盒也能帮您的忙,只需500个左右的细胞即可提取全基因组DNA。 2. 杂交DNA的准备:a) PCR引物设计:一般扩增产物长度为300~600 bpb) PCR扩增:获得杂交DNA 3. Cruiser™酶筛选阳性克隆:无需纯化DNA,直接使用PCR产物,混合体系后45℃下反应15~20 min K562细胞
技术资料